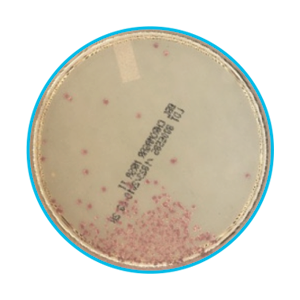

RELATED PRODUCTS NOT AVAILABLE
true
BD Kiestra™ MRSA Application
BD Kiestra™ Methicillin-resistant Staphylococcus aureus (MRSA) Application


- Overview
- Products & Accessories
- EIFU & Resources
An AI-developed application that enables high resolution, standardized plate imaging to deliver laboratory efficiencies and advanced image analysis

User-created expert rules using patient demographics or test results drive a consistent workflow

Batch report no growth samples

Validated media for automated growth detected on BD BBL™ CHROMager™ MRSA II medium
Color recognition to enable mauve color growth detection without confirmation testing*
BD Diagnostic Solutions is Now Waters Advanced Diagnostics
BD Diagnostic Solutions and Biosciences have combined with Waters Corporation to create a life sciences and diagnostics leader driven by innovation and a relentless commitment to our customers.
As we begin our new journey as part of Waters, there will be no immediate changes in how we serve you. The way you order your products and services and how you process payment for them will not change. Your points of contact for sales, customer service, technical service and support or clinical services will remain the same.
true
Literature
Our collection of literature on industries and on our offerings gives you information you can use to continue striving for excellence.
Learn more
true
Literature
Our collection of literature on industries and on our offerings gives you information you can use to continue striving for excellence.
Learn more
true
*for anterior nares specimens only
Disclaimer:
This business has been acquired by Waters Corporation (“Waters”). For products referenced on this page, the legal manufacturer remains Becton, Dickinson and Company or one of its affiliates or subsidiaries (“BD”) until all required regulatory transfers are completed. During this interim period, BD maintains full responsibility for all regulatory obligations of the legal manufacturer. Product information provided here is supplied under the regulatory authority of BD. To learn more about the relationship between Waters and BD during this transition period, please see our detailed summary waters.com/bdtransaction.
true